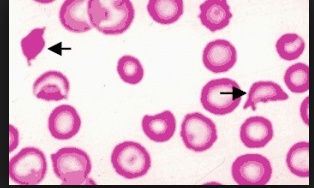

Preeclampsia
Chronic HTN
_Normal BP:
Systolic: 100 - 139
Diastolic: 60 - 89..
_Hemorrhagic stroke is the biggest concern/risk with hypertension..
_Chronic Hypertension: HTN (BP ≥ 140/90 mm Hg)..
Before pregnancy
Before the 20th week of gestation
Persists after postpartum period (>12 weeks post-delivery)
Hypertensive urgency and emergency
_..
Urgency: 220/110; HTN meds and send home
Emergency: 220/110 and end organ damage; ER admission
_Preeclampsia is a hypertensive emergency because of proteinuria, kidney damage..
Gestational Hyptertension
_Pregnancy-induced hypertension that:
Commonly presents after 20 weeks gestation, and can also be seen up to 6 weeks postpartum.
No pre-existing hypertension
No proteinuria or end-organ damage.
Note: the abrupt onset of hypertension before 20 weeks suggests molar pregnancy..
_..
Gestational Hypertension
BP > 220/110
Preeclampsia
Gestational HTN + proteinuria
Eclampsia
Preeclampsia + seizure
Preeclampsia
FLT
_VEGF receptor in placenta., They become sFLT in soluble form
_..
Genetic predisposes FLT to become sFLT that float around in blood stream and absorb available VEGF. This leads to loss of VEGF action that are needed to transform cytotrophoblast to endothelial cell and remodelling of spiral arteries necessary for placental growth.
This leads to toxin secretion that leads to:
endothelial leakage resulting in proteinuria and ischemia
increased vasoconstrictors and decreased vasodilators resulting in vasospasm and hypertension
placental ischemia resulting in coagulation abnormalities

_The clinical presentation includes the following:
Blurred vision
Abdominal pain
Edema of the face and extremities
Altered mentation
Hyperreflexia.,
_There is an increased incidence in patients with:
Preexisting diabetes mellitus
Hypertension
Chronic renal disease
Autoimmune disorders (lupus)
First pregnancy
less than 20 or greater than 35 age.,
Preeclampsia Treatment
_For chronic, oral therapy of HTN in pregnancy, the recommended drugs are:
α-Methyldopa
Labetalol
Nifedipine..
α-Methyldopa
_Acts on α2 (Gi) autoreceptors to inhibit NE release. Has a long history of safety for the mother and the fetus.,
Labetalol
_α1-blocker in VSMC, causing vasodilation. Different racemic components also act as a non-selective ß-partial agonist with some ß-blocking activity as well.,
Nifedipine
_L-type calcium channel blocker of the vascular type.,
Stabilize the Mother with anti-HTN medications (labetalol, hydralazine, nifedipine)
Prevent seizure with MgSO4
Deliver the placenta.,
Although methyldopa is available as a parenteral preparation, acute and accurate control of blood pressure is better with labetalol or hydralazine. However, if nothing else is at hand, it can be used. Drug choice depends on availability and experience with a particular drug by the physician.
_Seizure in eclampsia is self limiting. It will go away in 3-5 minutes. You don't need to treat that; only need to prevent it from happening with MgSO4..
_Use urine output as indicator for effectiveness of treatment..
Hydralazine
_Works via smooth muscle cell vasodilation:
Blocks IP3, Ca release
Releases NO via cGMP.,
MgSO4
_Antagonizes the activity of calcium. Prevents origination of seizures by reducing activity of iGlut (glutamatergic, NMDA, calcium ionotropic neurotransmission)., Mg also reduces vasospasm and reverses oliguria and edema by antagonizing calcium (takes up to 2 days). However, its effect on blood pressure levels is slow via volume reduction and relief of vasospasm. That is why you need the anti-HTN drugs to quickly reduce threat of stroke from high BP.
_Overdose of Mg reduces excitability of CNS, resulting in loss of patellar reflex, respiratory and cardiac arrest. First symptom is decreased capillary reflex. In overdose,MgSO4 may produce nephrotoxicity of its own because of its renal clearance. In overdose, treat with calcium gluconate IV injection. Do not use antiepileptic medications for seizure control. MgSO4 is sufficient for seizure control and prophylaxis..
Less than 28 weeks
_No fetal viability
Stabilize mother and give dexamethasone to delay pregnancy
If mother cannot be stabilized, deliver baby.,
28 to 34 weeks
If life of mother is threatened, deliver the baby.,
Try to maintain pregnancy to at least 34 weeks, when dexamethasone is no longer needed
37 to 41 weeks
_ Official full term baby.,
More than 41 weeks
_.. Post term at 41 weeks. Induce labor via:
Oxytocin drip: uterine contraction
Dinoprostone: PGE2, cervical dilation
HELLP Syndrome
_Stands for Hemolysis, Elevated Liver enzymes, Low Platelets..
_A very serious complication of pregnancy-induced hypertension. It usually only occurs with severe preeclampsia. Can lead to hepatic subcapsular hematomas, which can rupture and result in severe hypotension.,
Laboratory findings show thrombocytopenia and hyperuricemia
Peripheral blood smear shows schistocytes
Treatment: immediate delivery
Pathogenesis
_Platelet thrombosis in liver shears RBC, leading to hemolysis and low platelet counts. Resulting liver infarct from low O2 leads to increased liver enzymes.,
Last updated
Was this helpful?